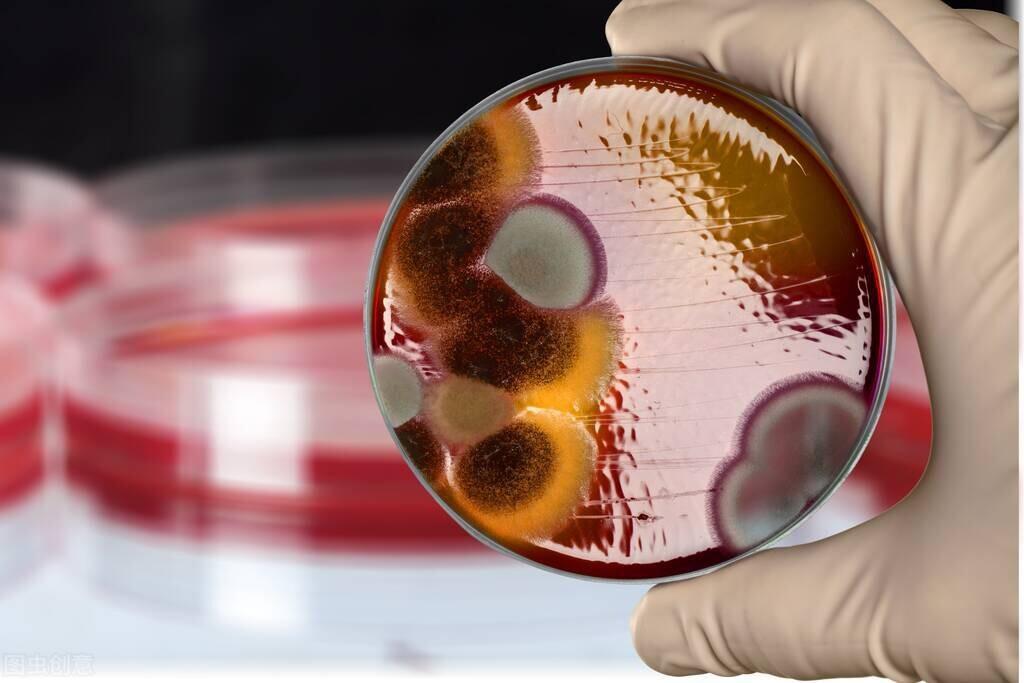

世界十大剧毒
哈喽,大家好我是小编阿拉
大家知道世界上最毒的物质是什么吗?不是砒霜,也不是百草枯,世界上最毒的物质,只要一克的量,就可以毒杀全人类,认真看完这篇文章,你会对世界上的毒药有一个全新的认知。
第十名:氰化物
这是一种经常出现在侦探小说里的毒药,拥有极强的毒性和极快发作的特性,中毒后,刚开始你会感觉到头晕眼花、视线模糊,紧接着会出现上吐下泻的症状,这就是氰化物开始在体内反应的作用,紧接着致人于死地像我们平时吃过的苹果,李子等水果,他们的果核内就含有少量氰化物,因为含量过低,所以对人们没有什么危害,氰化钾的致死量在50mg-250mg之间。

第九名:尼古丁
这个东西大家肯定都不陌生,尼古丁是香烟里的必备成分,不仅能够舒缓心情,还能够提神醒脑,因为每支烟的尼古丁含量很少,但当他被提纯时,注射到人体静脉里之后,毒性就显现出来了,中毒之后中毒者的血管会收缩,血小板凝聚。从而导致心血管堵塞,致死时间为3-5分钟,比氰化物稍慢,但是1g的量就能毒死几百人。

第八名:相思子毒素
这是一个长相类似于红豆的植物,但他并不能吃,它含有的剧毒,在人们吃了之后,短时间内不会发作,要等几天之后才会觉得有些恶心、昏迷、腹痛、内脏溃烂等状况,最后导致呼吸衰竭,脏器溃烂致死,1g的毒素能导致一千多人死亡。

第七名:二恶红
这是一种比砒霜毒上900倍比鹤顶红毒上千倍的剧毒化合物,需要含氯物质经过高温燃烧后才能产生,当人体中毒后,会迅速赶到身体不对劲,因为这种物质会将人的免疫系统迅速破坏的,有中毒严重的病患,因此患上癌症,如果说前面我们所说的三种毒性恐怖,那么这种物质会比他们更加恐怖,这种物质的毒素还具有遗传性,1g的量就可导致一万人去世。

第六名:眼睛王蛇毒素
这种毒素比较神奇,神奇的地方就在于,如果把毒液直接喝下,那什么都不会发生,但如果被毒素接触到了伤口,进入到你的血液,进行了体液循环,不久之后就会一命呜呼,他不仅会导致你的体内器官出血,还会导致呼吸系统衰竭大脑衰竭,会让中毒者,在无尽痛苦中死去。

第五名:蓖麻毒素
农村的朋友对蓖麻并不陌生,因为这个东西他在农村算是一种常见的食物,但蓖麻的种子却是真正的剧毒之源,1g的量就可导致三万人一命呜呼,如果误食了蓖麻子,三个小时内喉咙就会感到不舒服,还办有肠胃反应,最后就是肝脏出血等,如果误食蓖麻子一定要及时送到医院去进行抢救。

第四名:沙林毒气
这是一种无色但有味的神经性毒气,不要以为毒药的味道都很刺鼻难闻,沙林毒气的味道是水果香味,曾被人类作为生化武器,中毒后会瘫痪,瞳孔收缩,肠胃剧痛,最后在剧烈的痛苦中去世,1g就让导致四万人一命呜呼。

第三名:炭疽病毒
相比我们常见的砒霜,水银等毒素,炭疽病毒属于一种非常可怕的生物武器,它能够引发炭疽病也叫炭疽热,不仅传染性极高,还会导致人体细胞大面积死亡,最后呼吸困难,脾脏肿大等症状,在二战时期,就有国家使用这种武器1g含量就可导致七万人去世。
第二名:肉杆菌毒素
有的生猪肉钟含有一种肉杆菌分泌出的肉杆菌毒素是世界上最毒的东西之一,想不到吧,这是你生活中,很容易碰到的东西,也是人类所知道的天然毒素和合成毒素中毒性最强的生物毒素,根据相关专家研究,一亿分之七克的肉杆菌毒素就可以毒死一名年轻人。

第一名:钋
和肉杆菌毒素不同,这一物质大家只能在元素周期表见过,这是目前人类发现的最毒的物质,0.1g就可以消灭全人类,因为它可以通过核反冲作用形成放射性气溶胶,从而对环境空造成污染,甚至能从你的皮肤毛孔里透进去,所有的钋都是密封保存的,有相关专家进行研究过,人体承受的钋不能超过一万亿分之零点八克,简单换算一下就是0.1g的钋能消灭掉一千亿人类,可现在地球也只有七十亿人口这也就是说它不需要1g就能消灭全人类的原因。

本期文章到这里就完结了,看都看到这了,免费的关注和赞麻烦您给点一个呗,小编下期给您带来更精彩的文章,谢谢您的阅读!有不同想法的欢迎大家下方留言。


还没有内容